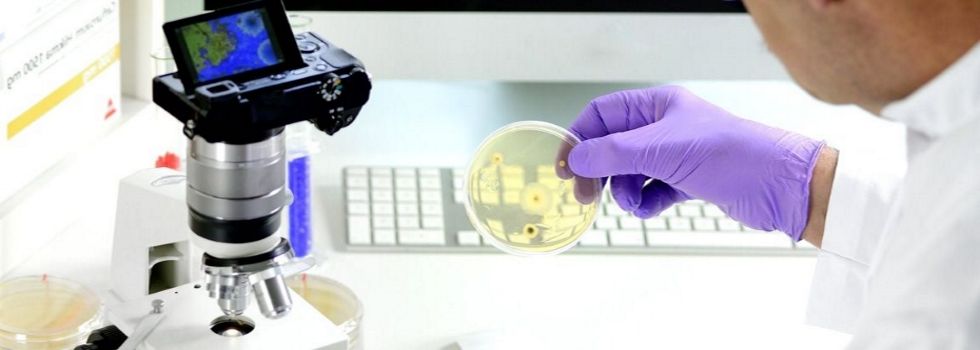

Mikroskop- Eine faszinierende Welt der kleinen Dinge
Es ist faszinierend in einen Mikrokosmos eintauchen zu können und Objekte betrachten zu können, die mit dem bloßen Auge nicht erkennbar sind. Dieses Betrachten und Erforschen von kleinen, mit der „normalen“ Sehkraft nicht erkennbaren Objekten wird mithilfe eines Mikroskops ermöglicht.
Ob Sie für den Beruf, die Ausbildung, Schule, Forschung, Wissenschaft oder das Hobby ein Mikroskop kaufen möchten, es gibt für vielfältige Zwecke mit unterschiedlichen Vergrößerungsmöglichkeiten und Qualitäten das passende Mikroskop.

Zellen – Bild: © Kateryna-Kon – Fotolia.com
Mikroskope sind nach physikalischen Regeln der Optik mit älterer oder moderner Technik ausgestattete Geräte, die es ermöglichen weitaus kleinere Details an Objekten sichtbar zu machen, als es beispielsweise mit einer Lupe möglich ist.
Grob beschrieben kann die Arbeitsweise eines Mikroskops beschrieben werden als ein heranzoomen von kleinen Objekten an das menschliche Auge. So können mithilfe von Mikroskopen die äußeren und auch inneren Strukturen beispielsweise von Metallen, Steinen, Hölzern, Blättern, Insekten und vielen anderen Dingen sichtbar gemacht werden.
Selbst Blutkörperchen oder Bakterien und noch kleinere Bestandteile auch von lebenden Organismen können mit einem Mikroskop vergrößert und damit für das menschliche Auge erkennbar werden.
Mikroskope haben es dem Menschen erst ermöglicht, die faszinierenden Wunder der natürlichen Umgebung vollständig erfassen zu können.
Der Name „Mikroskop“ stammt aus der griechischen Sprache, mit dem Wort „mikrós“ für „klein“ und dem „skopeín“ für „betrachten“. Mikroskope finden in vielen Bereichen, wie beispielsweise den Naturwissenschaften, der Medizin, der Materialkunde und -prüfung oderauch als faszinierendes Hobby von Kindern oder Erwachsenen Anwendung.
Kleiner Überblick über die verschiedenen Techniken und Arten der Mikroskope
Es gibt verschiedene Arten an Mikroskope, die unterschiedlich hohe Auflösungen erreichen können. Schon im 16. Jahrhundert wurde die sogenannte Lichtmikroskopie von niederländischen Brillenschleifern sowie Linsen- und Glasmachern entdeckt.
Die ersten Mikroskope mit einer schon beachtlichen Vergrößerung durch eingesetzte fein geschliffene Linsen wurden von den beiden Holländern Zacharias Janssen zu Beginn 17. Jahrhundert und ungefähr 50 Jahren später von Antoni van Leeuwenhoek entwickelt.
Bei dieser Technik wird das Objekt entweder durch eine einzelne oder mehrere hintereinander gefügte Glaslinsen vergrößert. Die maximal erreichbare Vergrößerung ist abhängig von der Wellenlänge der verwendeten Lichtquelle und liegt ungefähr bei 0,2 Mikrometern.

Foto: © geralt – pixabay.com
Am Ende des 19. Jahrhunderts wurden die physikalischen Grenzen für eine Vergrößerung dieser Art durch den Wissenschaftler Ernst Abbe als „Abbe-Limit“ beschrieben.
Nach 1963 konnten lichtmikroskopische Techniken entwickelt werden, die eine höhere Auflösung als das von Abbe bezeichnete Limit erreichten, beispielsweise mit dem 3D-SIM-Mikroskop, dem STED-Mikroskop und dem 4pi-Mikroskop. Die Erläuterung der einzelnen Funktionsweisen im Detail würde an dieser Stelle zu weit führen.
Bereits ab 1930 wurde das Elektronenmikroskop entwickelt, das eine höhere Auflösung durch die niedrigeren Wellenlängen von Elektronenstrahlen entgegen Lichtwellen. Eine weitere Möglichkeit kleine Dinge optisch erfassbar zu machen, wurde mithilfe der Rasterkraftmikroskopie entdeckt.
Bei dieser Technik werden Gegenstände an der Oberfläche abgetastet und in einer Vergrößerung dargestellt.
Top 3 Mikroskope
Bresser LCD-Mikroskop 50x-500x (2000x digital), 5 Megapixel, 8.9cm (3.5
269,84 €*inkl. MwSt. *am 21.08.2023 um 16:51 Uhr aktualisiertSeben Incognita Stereo Mikroskop 20x+40x+80x Vollausstattung
Preis nicht verfügbar
*am 21.08.2023 um 16:51 Uhr aktualisiertBresser Mikroskop – 5110000 – Erudit MO 20x-1536x
Preis nicht verfügbar
*am 21.08.2023 um 16:51 Uhr aktualisiert
Bresser LCD-Mikroskop 50x-500x (2000x digital), 5 Megapixel, 8.9cm (3.5
Seben Incognita Stereo Mikroskop 20x+40x+80x Vollausstattung
Bresser Mikroskop – 5110000 – Erudit MO 20x-1536x
Grundbausteine von handelsüblichen Mikroskopen
Wenn Sie ein handelsübliches Mikroskop kaufen möchten, werden Sie in den häufigsten Fällen ein Mikroskop mit einer gewissen Grundausstattung erhalten. Zu den  Grundbausteinen gehören beispielsweise:
Grundbausteinen gehören beispielsweise:
- das Stativ
- das oder die Okularen
- die Objektive
- der Objekttisch
- die Lampe
Durch die zylinderförmigen Okulare können die Objekte betrachtet werden. So kann ein Mikroskop mit einem oder mit zwei Okularen ausgestattet sein. Die Öffnung und die Linsen der Okulare entsprechen ungefähr dem Durchmesser des menschlichen Auges.
Das Blickfeld durch die Okulare wird horizontal direkt auf das auf dem Objekttisch liegende Objekt gerichtet und ermöglicht so das Betrachten des zu erforschenden Gegenstandes.
Das oder die beiden Okulare sind am oberen Ende des Stativs angebracht. Das Objektiv ist mit einer oder mehreren Linsen ausgestattet, die erst die Vergrößerung des Objektes ermöglichen. Der Objekttisch liegt unterhalb der Okulare und des Objektivs. Auf diesem Objekttisch werden die zu betrachtenden Untersuchungsgegenstände platziert werden.
Größere Objekte können dabei direkt auf den Objekttisch gelegt werden. Für kleinere Dinge oder Substanzen werden kleine Glasplatten mithilfe von Objektträgern genutzt.
Die Objekte werden zwischen die Glasplatten aufgebracht und diese von den Objektträgern zusammen geklammert. Dieses Einfügen der Objekte zwischen die Glasplättchen und das Festklammern dient der Verbesserung der Bildqualität und dazu, dass die Objekte während des Mikroskopierens nicht verrutschen können.
Die im Handel üblichen Geräte, die Sie als Mikroskop kaufen können, basieren nahezu allesamt auf der Lichtmikroskopie. So sind die Mikroskope mit einer Lampe versehen, die den zu mikroskopierenden Gegenstand oder die Substanz von unten oder auch von oben an- oder durchleuchten. Erst durch das Licht wird das Arbeiten mit diesen Mikroskopen möglich.
Verschiedene Typen in der Kategorie der Lichtmikroskope
Wenn Sie im Handel ein Mikroskop kaufen möchten, fällt dieses mit großer Wahrscheinlichkeit in die Kategorie der Lichtmikroskope. Die oben beschriebene Grundausstattung ist bei all diesen Mikroskopen vorhanden, dennoch gibt es verschiedene Modelle mit weiteren unterschiedlichen Ausstattungsmerkmalen:
-
monokulare und binokulare Mikroskope
Mikroskope können mit einem einzelnen Okular oder mit zwei Okularen für beide Augen ausgestattet sein. Eine neue Variante der im Handel erhältlichen Mikroskope setzen anstatt oder zusätzlich einen LCD-Bildschirm zum Betrachten des mikroskopierten Objektes ein.
-
Vor- und Nachteile von monokularen und binokularen Mikroskopen
Monokulare Mikroskope verfügen eigentlich nur über den Vorteil, dass sie oftmals zu günstigeren Anschaffungspreisen erhältlich sind, als binokulare Mikroskope.
Sollten Sie nur gelegentlich ein Objekt in einem Mikroskop betrachten möchten, kann es vollkommen ausreichend sein, wenn Sie ein monokulares Mikroskop kaufen.
Wer allerdings das Mikroskop häufiger nutzen möchte, ist mit einem binokularen Mikroskop besser beraten. Um mit einem monokularem Mikroskop gut sehen zu können, muss das eine Auge geöffnet und das andere Auge geschlossen gehalten werden. Dieses kann auf Dauer nicht nur sehr anstrengend sein, sondern kann sich auch ungünstig auf die Gesundheit auswirken.
Das einseitige Augenzukneifen kann Muskelverspannungen und auch Kopfschmerzen auslösen. Die Durchblutung in dem nicht genutzten Auge – dem zugekniffenen Auge – kann bei häufiger Nutzung des Mikroskops verringert werden. Dadurch können die Netzhaut oder Nervenbahnen geschädigt werden und eine Verminderung der Leistungskraft des nicht genutzten Auges bewirken.
Beim binokularen Mikroskop hingegen verändert sich die Qualität des Bildes nicht. Das menschliche Gehirn ist in der Lage, das mit beiden Augen wahrgenommene in seinem Gewicht für ein gutes Sehergebnis auf ein Auge zu legen. Dadurch verliert das durch ein binokulares Mikroskop Gesehene nicht an Schärfe oder Ähnliches.
Die Nutzung ist für Anfänger teilweise nur erst einmal etwas ungewohnt, aber die Augen, das Gehirn und das Sehen stellen sich nach recht kurzer Zeit darauf ein, mit beiden Augen durch die beiden Okulare zu schauen.

Mikroskop mit Computer – Bild: © tilialucida – Fotolia.com
-
einfaches Mikroskop und digitales USB Mikroskop
Ein einfaches Mikroskop bietet nicht die Möglichkeiten das Gesehene festzuhalten, außer vielleicht durch schriftliche Aufzeichnungen und Notizen. Die digitale Technik bietet auch bei den Mikroskopen eine Vielzahl an modernen Erweiterungen und Möglichkeiten. So können die Objekte auf einem kleinen LCD-Monitor anstatt durch Okulare betrachtet werden.
Die Bilder können digital festgehalten werden und über einen USB-Anschluss auch auf einem größeren Monitor oder einen Fernseher angesehen werden.
Alle technischen Möglichkeiten der digitalen Datenübertragung, Datenspeicherung und Bildbearbeitung stehen dann auch für die Bilder der mikroskopierten Objekte zur Verfügung.
Von großer Bedeutung kann dabei die Speichermöglichkeit sein und eine große Arbeitserleichterung darstellen, beispielsweise bei Vergleichen von Objekten, dem dokumentieren von zeitlichen Entwicklungen bei Objekten aus der Natur oder Ähnliches sein.
Die meisten digitalen USB Mikroskope verzichten vollständig auf Okulare und sind nur mit einem LCD-Bildschirm ausgestattet. Modelle, die über beides – Okular und LCD-Bildschirm – verfügen, werden seltener vom Handel angeboten.
Für welchen Typ Sie sich entscheiden sollten, wenn Sie ein Mikroskop kaufen, hängt von den verschiedenen Anforderungen ab, beispielsweise für welchen Zweck Sie das Mikroskop nutzen möchten, ob Sie nur gelegentlich ein Objekt betrachten möchten oder als (Hobby-)Forscher häufig verschiedene Gegenstände mit dem Mikroskop untersuchen möchten, ob Sie ein Anfänger-Mikroskop für Ihr Kind oder ein technisch weit entwickeltes Modell für sich selbst anschaffen, ob Sie Ihre Untersuchungsbilder digital festhalten, speichern, visuell bearbeiten oder auf einem größeren Monitor betrachten möchten und von den unterschiedlichen Anschaffungskosten.
Die Anschaffungskosten können je nach Ausstattung und Qualität der Mikroskope verschiedener Hersteller sehr variieren.
-
das Stereomikroskop
Stereomikroskope vergrößern Objekte dreidimensional. Sie bieten eine spannende Möglichkeit, verschiedene Objekte nicht nur als zweidimensionales Bild, sondern in ihrer dreidimensionalen Gesamtheit zu erfassen. Diese Mikroskope sind auch sehr beliebte Alternativen zu Lupen oder anderen Vergrößerungsgläsern bei Sammlern, beispielsweise von Steinen, Mineralien, Münzen und Ähnlichem.
Auch für Kinder kann das Betrachten von verschiedenen Gegenständen unter einem Stereomikroskop ein faszinierendes Erlebnis sein. Das Stereomikroskop arbeitet als spezielles Lichtmikroskop nach einer besonderen Technik, die für jedes Auge einen eigenen sogenannten Strahlengang zur Verfügung stellt.
Das Objekt oder Präparat wird unter verschiedenen Winkeln gesehen und durch dieses spezielle Sehen stellt sich bei der Vergrößerung ein räumlicher Effekt ein.

Mikroskop an einem Computer angeschlossen – Bild: © ktm_2016 – Fotolia.com
-
Life-Science-Mikroskope
Life-Science-Mikroskope werden auch biologische Mikroskope genannt. Sie sind mit monokularer, binokularer sowie trinokularer Ausstattung erhältlich. Trinokular bedeutet, die Mikroskope haben in den häufigsten Fällen einen monokularen Einblick und einen trinokularen Strahlengang, bzw. drei Strahlengänge.
Sie können auch digital mit einem LCD-Bildschirm ausgestattet sein.
Die Einsatzbereiche für biologische Mikroskope sind beispielsweise in der Forschung, Biologie, Pflanzenkunde, Botanik, Insektenkunde, Mineralogie, Gemmologie und anderen Bereichen zu finden.
Die Untersuchungen der Präparate, Proben oder Objekte können beispielsweise mit Durchlicht oder Auflicht ausgeführt werden, bei Vergrößerungen von beispielsweise um den Faktor 20 bis 1000.
-
Metallurgische Mikroskope
Durch den Einsatz verschiedener Linsen und Lichttechniken können Mikroskope erstellt werden, die sich besonders gut für unterschiedliche Kategorien an Objekten oder Präparaten eignen, wie beispielsweise metallurgische Mikroskope bei der Betrachtung von Oberflächen, die kein Licht durchlassen.
Diese Art Mikroskope werden zum Beispiel in der Qualitätskontrolle und Materialprüfung, in der Mineralogie, in der Metallurgie, in der Untersuchen von textilen Geweben, Untersuchung und Prüfung von Halbleiterscheiben in der IT-Branche, Kunststoffen in verschiedenen Branchen, wie beispielsweise in der Baubranche und in vielen weiteren Bereichen verwendet.
-
Mikroskope mit polarisiertem Licht
Das polarisierte Licht verfügt über eine andere Schwingungsebene der Wellen. Im Gegensatz zu einer gewöhnlichen Lichtquelle können damit auch Objekte untersucht werden, die bei einer Richtungsänderung der Betrachtung über verschiedene Eigenschaften verfügen, wie beispielsweise Kristalle, Nervenfasern, Muskeln, pflanzliche Zellwände, Vogelfedern, Tierhaare und Weiteres.
Diese Objekte werden auch als anisotrop bezeichnet, da sie eine bevorzugte Richtung ihrer Biomoleküle zeigen. Durch das polarisierte Licht können bei diesen Objekten Strukturen erkennbar gemacht werden, die mit einem „normalen“ Lichtmikroskop so nicht zu sehen wären.

Mikroskop und ein Monitor – Bild: © Paulista – Fotolia.com
Die verschiedenen Hersteller und Marken von Mikroskopen
Bevor Sie ein Mikroskop kaufen, das Ihnen optisch vielleicht auf den ersten Blick gefällt, kann es sinnvoll sein, die Angebote von verschiedenen Herstellern zu vergleichen. Die im Handel erhältlichen Mikroskope können unterschieden werden
– in sehr hochwertige und kostspielige Profi-Mikroskope, deren Einsatzzwecke beispielsweise im Beruf oder Studium liegen,
– in die günstigeren Hobby-Mikroskope, die für anspruchsvollere Erwachsene als Anfänger-Mikroskope konzipiert sein können, oder für Kinder als kleine Hobby-Forscher zum ersten Entdecken und Betrachten von Präparaten aus der Natur unter dem Mikroskop ausreichen.
Professionelle Mikroskope von verschiedenen Herstellern können oftmals auch in einzelnen Teilen gekauft werden, wie beispielsweise verschiedene Stative, die mit Okularen, Prismen, Objektiven und weiterem Zubehör bestückt werden können.
Viele der Hersteller bieten unterschiedliche Modelle in den verschiedenen Qualitäts- und Preiskategorien an. Beispielsweise sind die Hersteller Zeiss und Leica bekannt für sehr hochwertige Profi-Mikroskope, haben aber auch günstigere Mikroskope für das Hobby in ihrem Programm. Das Unternehmen Bresser bietet günstige Mikroskope an und auch ein besonderes Galileo-Mikroskop-Set für Kinder oder Anfänger.
Die Marke Kosmos bietet faszinierende Mikroskop-Sets mit viel Zubehör für Kinder, beispielsweise auch Experimentierkästen und Selbstbau-Mikroskope. Weitere Hersteller von Mikroskopen mit einem sehr vielseitigen Angebot an Mikroskopen und Zubehör sind beispielsweise die Firmen und Marken: Reflecta, Xcsource, Somikon, Conrad, Clementoni, Hyundai, Kuenen, National Geographic und viele Weitere.
Von dem Unternehmen Andoer ist sogar für nur wenige Euro ein sogenanntes Taschenmikroskop mit einem Okular für eine Vergrößerung vom Faktor 60 bis 100 zu erhalten. Dieses Taschenmikroskop gilt auch eine Art Vergrößerungsglas oder Lupe beispielsweise für Exkursionen im Freien oder das Betrachten von Briefmarken oder Ähnliches.

Mikroskop – Bild: © stockyimages – Fotolia.com
Anfängermikroskope und Mikroskope für Kinder
Entdecken Sie die faszinierende Welt des Erforschens und Mikroskopierens, wenn Sie für sich und Ihr Hobby ein Mikroskop kaufen. Oder Sie unterstützen die Neugierde, den Forscher- und den Wissensdrang Ihrer Kinder, indem Sie ihnen das schon für die kleinsten Entdecker passende Mikroskop kaufen.
Mikroskope für Kinder werden oftmals in die Kategorien Mikroskope ab 8 bis 14 Jahre und „echte“ Mikroskope ab 14 bis 16 Jahre unterteilt. Aber auch andere Unterteilungen sind möglich.
Wichtig ist es bei der Anschaffung eines Mikroskops für Kinder, darauf zu achten, ab wann es dem Kind möglich ist, vielleicht mit der mehr oder weniger schwierigen Präzisionstechnik des Mikroskops umgehen zu können.
Bei jüngeren Kindern sind die Finger oftmals noch zu schwach und ungelenk, um die notwendigen Einstellungen ausführen zu können, wie beispielsweise den Grob- und Feinstellknopf bedienen zu können, ohne dabei das Mikroskop oder das Präparat zu schädigen.
Auch ein technisches Verständnis für die Vorgänge beim Mikroskopieren sollte beim Kind einigermaßen vorhanden sein, ohne es zu überfordern.

Mikroskop – Bild: © Olesia Bilkei – Fotolia.com
Ansonsten kann es passieren, dass das Kind die Freude an dem Hobby verliert und Sie ein teures Mikroskop kaufen, das am Ende ungenutzt in der Ecke steht.
Auch als Erwachsener oder für ältere Kinder, beispielsweise ab 14 bis 16 Jahre sollten Sie sich mit dem Umgang der Präzisionsmechanik vielleicht an verschiedenen Geräten verschiedener Hersteller vertraut machen, bevor Sie das Mikroskop kaufen.
Selbst Erwachsene können bei einigen Mikroskopen mehr oder weniger Schwierigkeiten haben die Einstellung so gut bedienen zu können, dass vernünftige und brauchbare Bilder entstehen. Wenn Sie als Anfänger oder für Ihr Kind ein Mikroskop kaufen, sollte dieses zu Ihnen oder Ihrem Kind passen.
„Echtes“ Mikroskopieren setzt auch den „richtigen“ Umgang mit dem Zubehör oder das Verständnis zum technischen Hintergrund, wie beispielsweise das Verstehen von zugehöriger biologischer oder technischer Fach- und Anleitungsliteratur voraus.
Aus diesem Grund wird ein Alter von mindestens 9 bis 14 Jahren, teilweise sogar erst ab 14 oder 15 Jahren für das Mikroskopieren als Hobby angegeben. Beim „echten“ Mikroskopieren kommen verschiedene zusätzliche Tätigkeiten für das Hobby hinzu, die ein bestimmtes Alter für einen sicheren Umgang voraussetzen, wie beispielsweise
– Sammeln von Objekten, Präparaten und Proben, beispielsweise mit einem Planktonnetz oder in Gläsern,
– das Lagern von Objekten, sowie das Herstellen und die Handhabung der kleinen Präparate,
– bei einigen Präparaten müssen kleine Schnitte mit Rasierklingen gemacht werden, beispielsweise durch Blätter und Pflanzenstängel.
Auch hierfür dürfen die Hände nicht zu klein und ungelenk sein, sowie ein bestimmtes Alter sollte für den sicheren Umgang mit den scharfen Rasierklingen vorhanden sein.
Wenn Sie für sich und Ihr Kind gemeinsam ein „echtes“ Mikroskop kaufen, kann es sehr sinnvoll sein, Ihr Kind, sofern es ein bestimmtes Alter noch nicht erreicht hat, nicht allein mit den gefährlicheren Gegenständen oder für die kleinen Hände zu kompliziertes Mikroskop umgehen zu lassen.
Vielleicht betrachten und erforschen Sie gemeinsam die spannenden Objekte und entwickeln mit Ihrem Kind zusammen ein schönes Hobby für eine sinnvolle gemeinsame Freizeitgestaltung.
Top 3 der Kinder Mikroskope
Bresser junior 8855001 Mikroskop-Set Biolux DE 40x-1024x USB
99,99 €*inkl. MwSt.Gewicht
798 g
Vergrößerung
40 x – 1021 x Pull Out Barlow Linse zum stufenlosen Zoomen
Batterien
3 x AA Batterien
*am 21.08.2023 um 16:51 Uhr aktualisiertBresser Junior Stereo Mikroskop 20x
69,90 €*inkl. MwSt.Größe
21,6 x 24,1 x 22,9 cm
Batterien
2 AA Batterien erforderlich
Gewicht
550 g
Vergrößerung
20 x
*am 21.08.2023 um 16:51 Uhr aktualisiertKOSMOS 636029 – Das große Forscher-Mikroskop
Preis nicht verfügbar
Gewicht
1,8 kg
Vom Hersteller empfohlenes Alter
12 – 16 Jahre
Produktabmessungen
48,5 x 33 x 18 cm
Batterien notwendig
ja
Batterien inbegriffen
nein
Typ Batterie
1,5 Volt / AA / LR6
Material
Metall ( Hauptsächlich)
*am 21.08.2023 um 16:51 Uhr aktualisiert
Bresser junior 8855001 Mikroskop-Set Biolux DE 40x-1024x USB
798 g
Vergrößerung
40 x – 1021 x Pull Out Barlow Linse zum stufenlosen Zoomen
Batterien
3 x AA Batterien
Bresser Junior Stereo Mikroskop 20x
21,6 x 24,1 x 22,9 cm
Batterien
2 AA Batterien erforderlich
Gewicht
550 g
Vergrößerung
20 x
KOSMOS 636029 – Das große Forscher-Mikroskop
1,8 kg
Vom Hersteller empfohlenes Alter
12 – 16 Jahre
Produktabmessungen
48,5 x 33 x 18 cm
Batterien notwendig
ja
Batterien inbegriffen
nein
Typ Batterie
1,5 Volt / AA / LR6
Material
Metall ( Hauptsächlich)
Worauf Sie achten sollten wenn Sie ein Mikroskop kaufen möchten

Mikroskop mit Objektträger – Bild: © nateejindakum – Fotolia.com
Die Auswahl an verschiedenen Modellen unterschiedlicher Hersteller an Mikroskopen ist sehr groß. Welches das passende Mikroskop für den Nutzer sein kann, ist abhängig von dem Einsatzzweck.
Mikroskope für Kinder und Schüler
Kinder sind vom Mikroskopieren oftmals sehr fasziniert. Einfache nicht sehr kostspielige Lichtmikroskope, beispielsweise mit einer Vergrößerung bis zum 400-Fachen, lassen kleine Pflanzenzellen oder kleine Organismen aus dem Wasser von Bächen, Weihern, Wasserpfützen oder Matsch entdecken.
In der Schule erhalten Kinder oft ab der 7. Klasse oder eher Unterricht im Umgang mit dem Mikroskop im Biologieunterricht. Um auch Zuhause mit dem Mikroskop arbeiten zu können oder die Begeisterung von kleinen naturwissenschaftlichen Forschern zu unterstützen, kann es sich lohnen, auch ein eigenes Mikroskop anzuschaffen.
Kinder- oder Juniormikroskope sind oftmals mit einem 10-fach Okular und Objektiven mit der 4-fachen, 10-fachen und 40-fachen Vergrößerung ausgestattet. Schülermikroskope verfügen häufig über zwei Okulare mit der 10- und 15-fachen Vergrößerung.
Drei oder vier Objektive mit verschiedenen weiteren Vergrößerungen gehören oftmals mit zu der Ausstattung.

Mikroskop im Labor – Bild: © Monet – Fotolia.com
Faszinierend für Kinder und Erwachsene können auch sogenannte Stereomikroskope sein. Sie sind etwas kostspieliger als einfache Junior- oder Schüler-Mikroskope, erzeugen dafür aber einen dreidimensionalen Eindruck des betrachteten Objektes.
In den häufigsten Fällen verfügen diese Mikroskope über zwei Okulare für das Sehen mit beiden Augen – also binokular – und eignen sich besonders gut zum Betrachten von Pflanzenteilen oder kleinen Lebewesen.
Die Vergrößerung ist in den häufigsten Fällen allerdings nur höchstens bis zum 40-Fachen möglich. Für Studium oder berufliche Zwecke sollten digitale Mikroskope oder sogenannte Trinokular-Mikroskope, bei denen drei Okulare genutzt werden können, in Betracht gezogen werden.
Noch zu beachten ist:
Je nach dem Zweck und dem Anspruch kann es einen mehr oder weniger großen Aufwand bedeuten, das passende Mikroskop zu finden. Besonders, wenn es sich um einen professionellen Anspruch handelt und Sie ein Mikroskop kaufen, das für berufliche Zwecke, Forschung in der Wissenschaft oder dem Studium, für betriebliche Einsätze, wie beispielsweise Materialprüfungen oder Qualitätskontrollen oder Ähnliches.
Aber auch wenn Sie ein Mikroskop kaufen für Ihr Hobby oder für Ihr Kind, ist es sinnvoll, wenn Sie sich mit verschiedenen Kriterien, wie beispielsweise Qualität, Ausstattung, Zubehör, Preis und Weiteres vor der Anschaffung beschäftigen.
So stellen Sie sicher, das für Ihren Anspruch und Ihre Zwecke passende Mikroskop zu finden und auch langfristig Spaß bei der Arbeit oder dem Hobby mit dem Mikroskop haben können.

Mikroskop mit Licht – Bild: © viktoriagavril – Fotolia.com
Wenn Sie ein Mikroskop kaufen möchten, sollten Sie auch auf die Art der Beleuchtung achten. Mikroskope sind mit Auflicht oder Durchlicht versehen, je nach Anwendung ist es sinnvoll das Objekt von oben oder von unten zu beleuchten.
Bei Mikroskopen mit Auflicht werden die Objekte oder Präparate von oben beleuchtet und Oberflächenstrukturen sichtbar gemacht.
Mikroskope mit Durchlicht beleuchten die Präparate von unten und das Licht scheint durch die Präparate hindurch. Die modernen Mikroskope sind zum größten Teil mit sparsamen und umweltfreundlichen LED-Leuchten ausgestattet.
Für die maximale Vergrößerungsmöglichkeit für Lichtmikroskope, unabhängig davon, ob es sich um ein normales oder ein digitales Mikroskop handelt, wird die sogenannte Größenspannweite angegeben.
Diese Größenspannweite liegt zwischen ungefähr 20 Millimetern und maximal 1300 Millimetern. In Bereichen über dieser Größenspannweite werden den Darstellungen der Bilder nur noch sogenannte „leere“ Einzelheiten hinzugefügt.
Für die Größenspannweite und damit die maximale Vergrößerungsmöglichkeit ist die Kombination von im Mikroskop verwendeten Okular und Objektiv verantwortlich.

Ein Blatt wird auf ein Objektträger gelegt – Bild: © jk1991 – Fotolia.com
Was weiterhin beachtet werden sollte – Qualität und Service
Die Qualität und Verarbeitung der Mikroskope ist in gewisser Weise auch vom jeweiligen Preis abhängig. Einfache Mikroskope für Kinder sind teilweise schon ab ungefähr 40 Euro erhältlich. Mikroskope mit höheren Vergrößerungsmöglichkeiten, digitale Mikroskope oder professionelle Mikroskope für Studium und berufliche Zwecke können schnell mehrere Hundert bis über Tausend Euro und mehr kosten.
Die Qualität der jeweiligen Mikroskope sollte eingehend geprüft werden. Sehr günstig ist es, wenn der Hersteller einen Service für Reparaturen oder zum Austausch einzelner Komponenten des Mikroskops anbietet.
Weiterhin sollte die Wahl des Mikroskops danach ausgerichtet werden, ob es fest an einem Platz steht oder öfter transportiert wird.
In letzterem Fall sollten Stativ und Fuß und der gesamte Mikroskop Aufbau nicht zu schwer sein. Wird das Mikroskop häufig genutzt, kann es sehr viel angenehmer sein, ein binokulares Mikroskop anzuschaffen.
Weiterhin wichtig ist es auch, auf die Qualität der Durchleuchtungsmittel des Mikroskops zu achten, wie gut die Lampe arbeitet und ob sie ausreichendes Licht liefert. Ebenso sollte die Lampe leicht zu wechseln sein.
Das vielfältige Zubehör von Mikroskopen als Kaufkriterium

Flüßigkeit auf Objektträger – Bild: © vetkit – Fotolia.com
Wenn Sie ein Mikroskop kaufen, kann auch die Ausstattung mit zusätzlichem Zubehör für Ihre Kaufentscheidung ein wichtiges Kriterium darstellen.
Zum Zubehör können beispielsweise Präparatklemmen, die das Objekt auf dem Objektträger fixieren können, eine gewisse Anzahl an Glasobjektträgern, Pipetten, Pinzetten, verschiedene Okular-Aufsätze oder Objektive, Anzucht-Sets und weiteres Zubehör gehören.
Sogenannte Tubus-Köpfe können sehr komfortabel sein. An diesen Tubus-Köpfen können unterschiedliche Linsen an mehreren Objektiven befestigt werden und diese lassen sich dann um 360° drehen.
Digitale mit einem USB-Anschluss versehene Mikroskope können als „Hightech Modelle“ sogar über integrierte Kameras verfügen, mit denen Fotos oder Videos von den mikroskopierten Objekten oder Präparaten aufgenommen werden können.
Für welches Mikroskop, mit welcher Ausstattung und welchem Zubehör Sie sich auch entscheiden möchten, hoffen wir, dass ihre Entscheidung durch diesen Artikel etwas einfacher geworden ist.